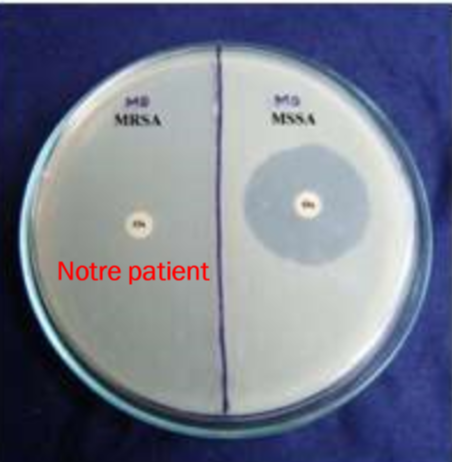

la vancomycine se donne sous quelle voie d’Administration ?
ca change quoi?
PO et IV
ca change TOUTTTTTT
PO–) pas absorbé–) JUSTE pou c.difficile
IV–) anti-gram + PURE
( inclue le SARM)

types d’infections habituellement causé par bactéries anaérobies ?
- intra-abdominales
- abcès
- colite

tu espere que ton patient ait quelle bactérie?
droite–) sensible aux antibio
pour 1 méningite,
est il vrai que tu pourrais donner de la péniciline anti-staphylococcique?
en IV c’est vrai
( c’est poussé )
quelles sont les principales classes d’Antibiotiques qui inhibent la synthèse des protéines( ceux vu enclasse)
- AMinosides
- macrolides
- clindamycine
donne les types d’infections normalement causé par gram +
- infection de la peau et tissus mous ( IMPORTANT)
- infection des os et articulations
- bactériémie et endocardite
pour une otite ou une sinusite quel classe d’Antibiotique est souvent prescrit?
les AMINOPÉNICILLINES

pour quels bactéries/infections que la metronidazoles est intéressante?
pour les ANAÉROBIES SEULEMENT!!!!!!!!
- infections intra-abdo
- abcès
- colite à c.difficile
- vaginose bactérienne
( pas oublier que inhibe la synthèse des acides nucléiques)

v/f un antibiotique et un antimicrobien qui tue les bactérie
faux
qui Tue les bactéries( bactéricide ) ou ralentit leur croissance ( bactériostatique(
v/f avant de faire la culture, on peut faire direct un examen direct et tester la sensibilité aux antibiotique de la bactérie
fauxxx!!
vrai qu’on peut faire un test direct —) coloration de gram
mais on doit attendre que pathogène soit isolé en culture pour tester la sensibilité au atb
compare la ciproloxine à la levofloxacine et la moxifloxacine
les 3 sont des quinolones!!( inhibent la synthèse des acides nucléiques)
CIPRO—) surtout pour inf. URINAIRES
LEVO/MOXI–) surtout infections RESPIRATOIRES

pour quelle raison que t’utiliserait un antibiotique à spectre étendue?
pas mis de s mais 2 raisons
- pck t’a as encore résultats de la culture ( traite selon le syndrome infectieux)
- pck infection POLYMICROBIENNE
comme tu sais que les céphalosporine ont AUCUN effet sur les enterococcus
quel antibiotique que t’utiliserait en première ligne?
AMINOPÉNICILLINE
quels sont les 3 grands mécanismes de résistances aux antibiotiques des bactéries? ( donne des exemples
- production d’enzymes modifiant l’ATB
- b-lactamase
- carbapénémase
2 -altération de la perméabilité de la membrane
- perte de porines
- pompe à efflux
ALTÉRATION de la cible
*
la confirmation par culture prend en général cmb de temps?
0pas exam mais interesting
48h
nomme une bactérie contre laquelle les céphalosporines sont inefficace
ENTEROCOCCUS

pour quelle raison que tu donnerait de la
cloxacciline?
clxaciline IV ou PO
—) pénicilline anti-staphylococciques
donc pour INFECTIONS au staphylocoquees

sur quelle composante de la bactérie que les vancomycine agissent ?
pk pas utilisé en première ligne?
sur la PAROI
c’est un glycopeptide!!!!!! ( b-lactamine agissent aussi sur la paroi)
2 ieme ligne ( b-lactamine avant)
car effets secondaires
- nephrotoxicité
- red man syndrome

quelles sont les types d’infections habituellement causé par les intracellulaire/atypiques?
- pneumonie acquise en communauté
- ITSS

sachant que les aminosides sont ANTI-GRAM négatif pure
pk t’es utiliserait dans le cas d’endocardites?
pck sont juste anti-gram - pck pas capable passer la paroi
si associe aminoside avec b-lactamine ( détruit la paroi)
il Y A SYNERGIE!!!!!!!

quelle est la différence entre l’Ampicilline et l’Amoxicilline
les deux sont des AMINOPÉNICILLINES
ampi= IV
amo=PO

les entérobactéries multirésistants sont autant résultant pk?
production de CARBAPÉNÉMASE
( b-lactamase à spectre étendue)
qui dégradent les carbapénèmes
donne les classes d’Antibiotiques qui agissent sur la synthèse de la paroi bactérienne
b-lactamine ( céphalosporines, péniciline, carbapénèmes, monobactome)
glycopeptides ( vancomycine)
quelles sont les voies d’Administrations des antibiotiques
- per os ( orale)
- IV
- IM ( intramusculaire)














